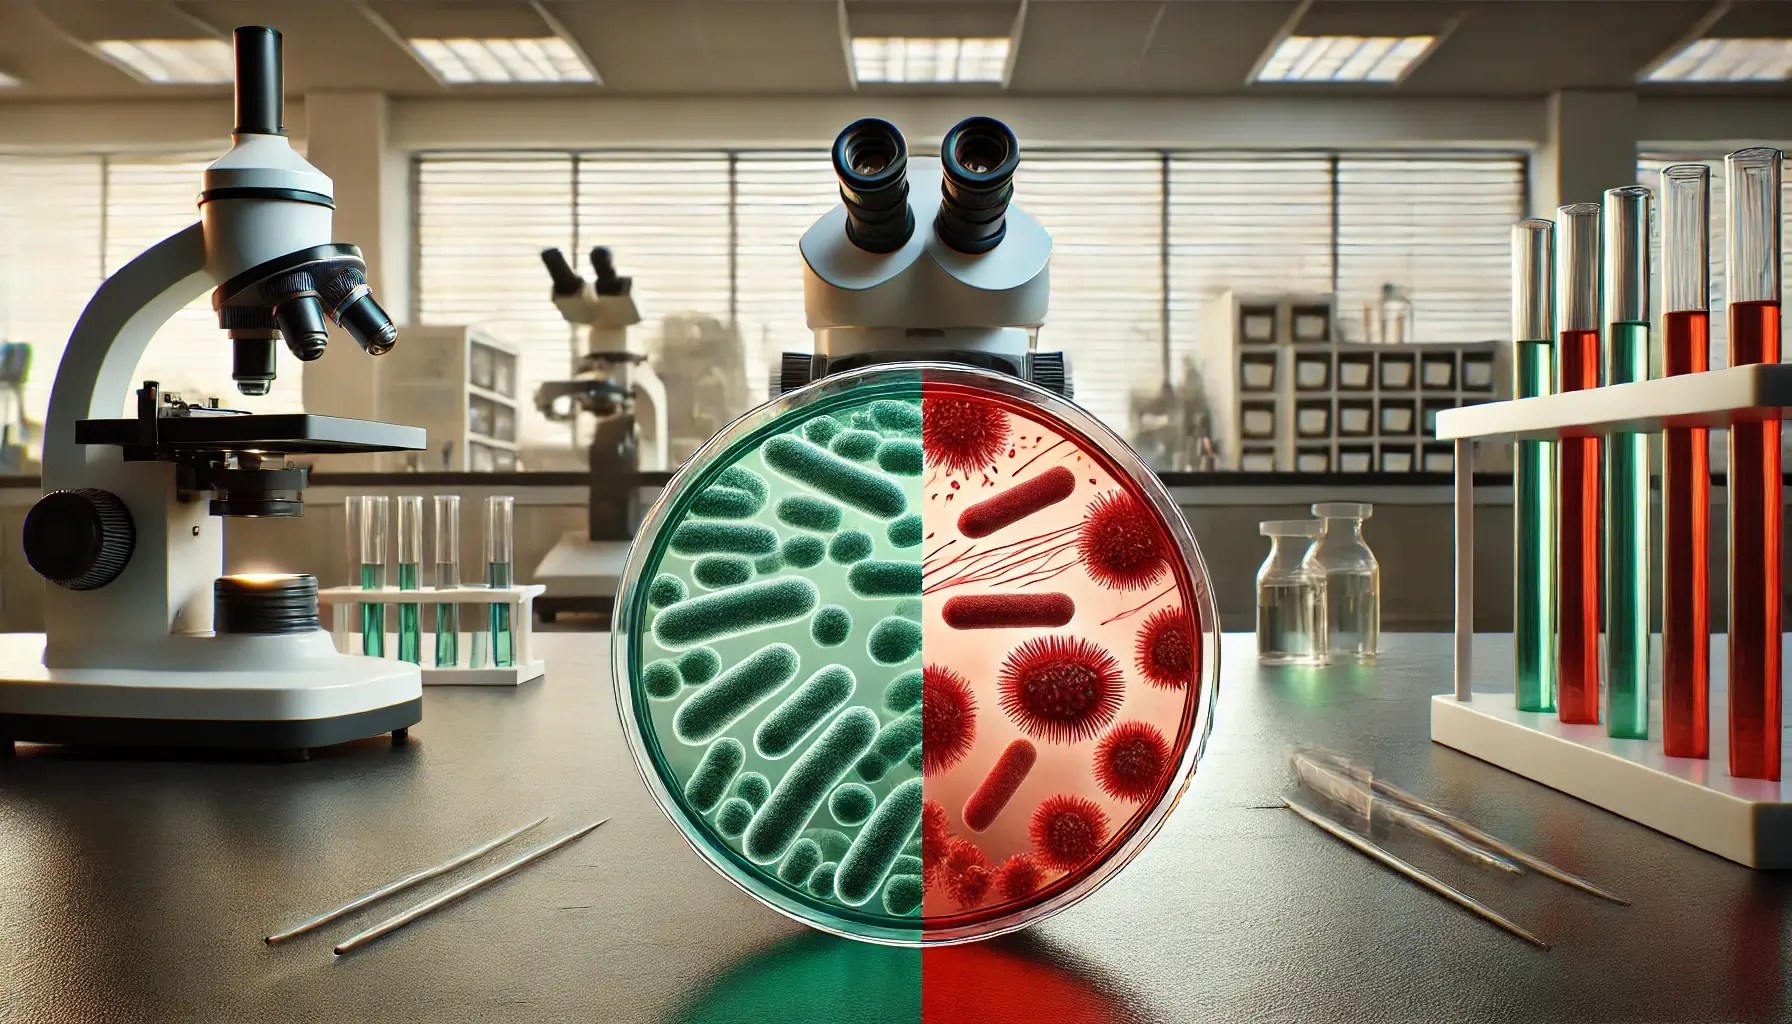

New compound combats flesh-eating bacteria, drug resistance to offer a breakthrough in the battle against antibiotic-resistant infections. As bacteria increasingly adapt to become resistant to treatments, the search for new, effective alternatives is a key factor.
Because of this global health emergency, scientists from the Washington University School of Medicine in St. Louis engineered the compound GmPcides. Early studies done have yielded promising results in general and, more interestingly, against a multidrug-resistant bacteria type causing necrotizing fasciitis-a disease commonly referred to as the “flesh-eating” disease-and it is caused by Streptococcus pyogenes. By being able to fight this kind of resistant pathogen, the treatment will be more effectively treated by GmPcide.
How This New Drug Fights Resistant Infections
This new drug targeted gram-positive bacteria, such as those responsible for this flesh-eating disease. Animal studies showed remarkable efficacy, most especially in dangerous and resistant strains. Because Necrotizing fasciitis destroys tissues so quickly in a patient, often leading to amputation, its mortality rate is around 20 percent-so new treatments like this hold a high value.
Animal studies show promise
In early tests on mice, it proved to be a powerfully antibacterial drug. It lessened the intensity of infections due to a common cause of flesh-eating disease, Streptococcus pyogenes. Treated mice showed fewer signs of infections and recovered sooner compared to ones that did not get any treatment.
Possible Use in Humans
Originally developed to inhibit the formation of bacterial films on medical devices, this new drug surprisingly turned out effectively to destroy bacterial membranes. This disruption makes the bacteria considerably weaker and less viable when trying to fight against human immune responses. Secondly, the new drug would generate less bacterial resistance-a highly favorable feature compared to the current use of antibiotics.
The Future of This New Drug
The new antibiotic compound against flesh-eating bacteria was patented by the researchers and is under development by QureTech Bio for possible clinical use. With antibiotic resistance continuing to loom over global health, the need for more innovative solutions in treatments for the future is pressing. For further details, please see the news page at Washington University School of Medicine.
For more information, visit the Washington University School of Medicine news page.